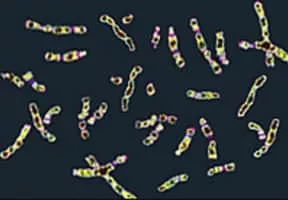

1000 Genomes Project
| Use attributes for filter ! | |
| Start date | January 2008 |
|---|---|
| Duration | January 2008 – 2015 |
| Date of Reg. | |
| Date of Upd. | |
| ID | 2304221 |
About 1000 Genomes Project
The 1000 Genomes Project, launched in January 2008, was an international research effort to establish by far the most detailed catalogue of human genetic variation.